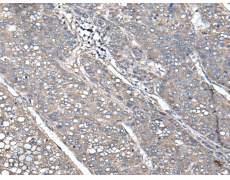
一抗

中文名稱: 兔抗UNC13B多克隆抗體
|
Background: |
This gene is expressed in the kidney cortical epithelial cells and is upregulated by hyperglycemia. The encoded protein shares a high level of similarity to the rat homolog, and contains 3 C2 domains and a diacylglycerol-binding C1 domain. Hyperglycemia increases the levels of diacylglycerol, which has been shown to induce apoptosis in cells transfected with this gene and thus contribute to the renal cell complications of hyperglycemia. Studies in other species also indicate a role for this protein in the priming step of synaptic vesicle exocytosis. |
|
Applications: |
ELISA, IHC |
|
Name of antibody: |
UNC13B |
|
Immunogen: |
Fusion protein of human UNC13B |
|
Full name: |
unc-13 homolog B |
|
Synonyms: |
UNC13; MUNC13; Unc13h2; munc13-2 |
|
SwissProt: |
O14795 |
|
ELISA Recommended dilution: |
5000-10000 |
|
IHC positive control: |
Human liver cancer and Human lung cancer |
|
IHC Recommend dilution: |
50-300 |


 購物車
購物車 幫助
幫助
 021-54845833/15800441009
021-54845833/15800441009